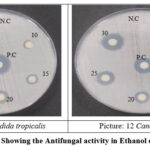

Antioxidant, Anti-inflammation, Antimicrobial Properties of Henckelia fischeri using HaCaT a Human Skin Keratinocytes
1Department of Botany, Nirmala College for Women, Coimbatore, Tamil Nadu, India.
2Department of Botany, Auxilium College (Autonomous), Vellore, Tamil Nadu, India.
Corresponding Author E-mail: amsv.kiruthika@gmail.com
DOI : http://dx.doi.org/10.13005/ojc/420132
ABSTRACT:Henckelia fischeri an endemic plant enrich with medicinal uses which in the family Gesneriaceae. It is used as a folk medicine for cold, cough and fever by the local people. The solvents ethyl acetate and ethanol is used for the study, where ethanol shows high results compare to the ethyl acetate. Antioxidant, anti-inflammation and antimicrobial activity is seen in different solvents of leaf extracts. The antioxidant assay was estimated with DDPH, FRAP and ABTS. The anti-inflammation was evaluated with Membrane stabilizing and anti-hemolytic assay. The bacterial strains used were Staphylococcus aureus (MTCC9760) and Enterococcus faecium (MTCC2729), Klebsiella pneumoniae (MTCC2403) and Salmonella typhimurium (MTCC3224). The fungal stains were Candida tropicalis and C.albicons. The bacterial and fungal strains were treated with different concentration i.e 10µl to 30µl, positive and negetative contol. This study also deals with the HaCaT Cell line which is skin human keratinocytes to prove the anti – aging property in it. The research work focus to evaluate the anti-oxidant, anti-inflammation and antimicrobial properties present in the selected medicinal plant and to record the cell activity acting against the aging property. And the results explains the phytopharmaceutical values of the plant.
KEYWORDS:Antioxidant; Antimicrobial; Anti-Inflammation; Ethyl acetate; Ethanol; HaCaT
Introduction
Plants has been a vital birth place of medicine from centuries, with a vast array of bioactive compound exhibiting antioxidant, anti-inflammatory and anti-microbial properties. According to WHO, medicinal plants are the vital source for many bioactive compounds. The increasing prevalence of genetic and chronic disorders like, heart diseases, intestinal problems, early maturation of skin and its disorders has led to a growing absorption in therapeutic prospective of plant-derived bio-based products.1 Oxidative stress, inflammation and microbial interactions are the essential factors benefaction to the development and progression of these aliments.
Antioxidant are the important material that human body needs naturally, and this antioxidant naturally produce by plants. Free radicals are an effective neutralization by antioxidants which prevents the cell and tissue from oxidative stress and damage. Similarly, Anti- inflammation is essential need to our human body because inflammation is not a deadly disease but the major issues faced by many peoples of the world. This inflammation may be the symptom of many diseases and sometimes it acts as a disease. Anti-inflammatory amalgamation help to regulate the natural defense, reducing Inflammation and promoting tissue repair.2 Elsewhere antimicrobial activity is the important property where it rules an essential role in the production of multiple diseases and it will also the necessity activity that each needs to fight against even basic diseases.3
The plant kingdom offers a rich source of antioxidants, antimicrobial and anti- inflammatory agents, including flavonoid components, compounds of phenolic acids, terpenoids, even in alkaloids. These phytochemicals have been shown to modulate various cellular pathways, including antioxidant defense systems, inflammatory signaling cascades, and cell survival mechanisms.4
Gesneriaceae family plants have an anti-skin diseases and anti-aging properties in them. This plant is also has a capacity to rule a work against early maturation. Hence this work also deals with the HaCaT cell and its viability. The HaCaT is a Human Skin Keratinocytes.5
Henckelia fischeri (Gamble) A. Weber & B. L. Burtt is a Gesneriaceae plant. It is locally known as “Parai otti”, the plant is commonly used for the diseases like fever, cold and cough by the local people. The plant is herbaceous and found in the southern Western Ghats of Tamil Nadu.
This research was designed to evaluate an anti-oxidant, Anti-inflammatory and antimicrobial activities of a choosed plant species traditionally used in (Traditional medicine/Local health practices). And also to enchance the cell viability in HaCaT cells. We employed various in vitro assays to understand an antioxidant, anti-inflammatory and antimicrobial potential of Henckelia fischeri extracts, with a focus on (Specific bioactive compounds or mechanisms).6 Our findings contribute to the understanding of the medicinal properties of Henckelia fischeri and highlight its capacity as a wellspring of natural antioxidants, anti-inflammatory and antimicrobial agents. This study gives an idea related cytotoxicity effect of HaCaT- Human Skin Keratinocytes. And this plant is not well explored in the research point of you. So the main hypothesis is to explore.
Materials and Methodology
Gathering and Determination of the sample
Sample is assemble from the Savarikkadu, southern Western Ghats of Tamil Nadu. The sample is collected with the help of local peoples. The authentication of the assembled medicinal plants is done in BSI of Coimbatore, Tamil nadu, India.
Study plant and its Medicinal Uses Systematic position
Class : Magnoliopsida (or) Dicotyledonae
Order : Lamiales
Family : Gesneriaceae
Genus : Henckelia
Species : H . fischeri
The genus Henckelia is available in North east area of Asian Continent and those are endemic to certain regions of India. 70 species in worldwide and 35 species found in India. The plant is perennials, rosette – forming and it is a hairy herbs with Rootstocks. The roota are adventitious and thin. Leaves are winged with 12-20 in numbers arranged 4 whorls. Flowers are small with Dark to pale lilac in colour. Capsules – cylindrical, straight or randomly curved. Seeds – numerous with dark brown in colour. Flowering will occur from the month of may to october whereas Fruiting will occur from the season July to December.7
Ethnomedicinal Uses
Commonly used for cold, cough and fever. But it also have properties like antioxidant, antimicrobial and anti-inflammation.
Sample Extraction
The leaves were cleaned under running water, allowed to dry in the shade at room temperature, and then ground into a fine powder. The extraction process begins with a pack of 30 grams of powdered dried leaf, treated with 300 milliliters of ethyl acetate and then the same powdered dried leaf is treated with 300 milliliters of ethanol that is soluble in a Soxhlet apparatus. The temperature is kept at its boiling point until the extraction is finished. Following the drying process of the plant’s extracted leaf sample, the crude was then gathered. Using the product, the additional analysis was completed.8
Anti-oxidant Investigation – Invitro
Quenching activity DPPH Assay
An antioxidant estimation was estimated with the donation of hydrogen or through the ability of radical scavenging. The samples were treated with different concentration along with the methanolic solution of DDPH. Here the standards used are BHA and BHT which was shaken vigorously. And the test tubes along with negative control was kept in 27ºC FOR 20 min. The sample was readed at 517nm along with blank. Here the blank act as a methanol.9
Scavenging activity ABTS Assay
ABTS Assay was sustained with the help of decolourization of samples. Taking of 2.4mM Potassium persulfate is mixed with 7mM ABTS aqueous solution which is diluted in ethanol and equilibrated at 30ºC which is readed at 734nm.10
FRAP Assay
Freshly prepared FRAP reagent was incubated for 37ºC. Again the sample is treated with distrilled water and methanol, after that it is incubated in water bath for 30 min at 37ºC. The optical density reading was calculated at 593nm along with the reagent blank in spectrophotometer at the end of incubation.11
Anti-Inflammatory Investigation – In vitro
Membrane-Stabilizing assay
Extract is incorporated with HRBC solution of 0.5ml and Hypotonic solution of 4.5ml which contains diverse concentaration of bergapten (10, 30, and 100 μg/ml). Triplicate is method of this demonstration. The combination is incubated for 10min in room temperature along with the positive and negative control. The centrifugation was also done at 3000 rpm at 10 min.The supernatant is considered as a hemoglobin content which is measured at 540 nm in spectrophotometer. The formulae used to estimate the percent of inhibition of hemolysis was12

Anti-hemolytic analysis
Evaluation of ferrous ion induced hemolysis in extracts were investigated. 2.5 μM ferrous sulfate is combined with RBC suspension was incubated with at 37°C for 30 minute then addition of phosphate buffered saline (PBS) 4 ml with the samples. The centrifugation was done at 2500 rpm for 5 min. The hemolysis were calculated with the use of spectrophotometer by at 540 nm. The control sample is calculated without the extract.13 Calculation of anti-hemolysis percent was done by the equation
% Inhibition = 100 × (1 – OD sample) / OD control
Antimicrobial Analysis
Strains of Bacteria
The Biotechnology Department from Bharathiar University located in Coimbatore on condition that the four strains of dangerous bacteria used in this study. The Strains of bacteria used are Staphylococcus aureus (MTCC9760) and Enterococcus faecium (MTCC2729), Klebsiella pneumoniae (MTCC2403) and Salmonella typhimurium (MTCC3224)
Disk Diffusion Method
The extraction of plant material was diluted in DMSO of 1ml. Muller Hinton agar were freshly make ready and an isolated organism were inoculated overnight in the Nutrient broth in a sterile condition. The plates used to lawn with swabs. The sterile discs contain 30µl of plant extract and then the plates are allowed to incubate overnight at 37ºC in a sterile condition.14
Antifungal Activity
Antifungal was done with the fungal Candida tropicalis and Candida albicons. A sterile filter paper disc at the concentration of 10mg/ml was taken. (14) And the method was done in triplicate and also repeated twice.
Development of Cell
The cell line HaCaT is an Human Skin Keratinocyte Cell Line which were secure from NCCS, Pune. Dulbecco’s Modified egale medium is the method which was used to yield the cell line in large scale. The cells are maintained in the media of DMEM along with 10% FBS and 1% anti-biotic anti-mycotic solution in the temperature, 5% Co2 and 18 – 20% of O2 at 37ºC for 3 days.15
MTT Assay
The major purpose of the analysis of is to determine the MTT Assay of Proliferation cell and its cytotoxicity, it is colorimetric assay. It is done based on the reduction of coloured yellow water soluble Tetrazolium Dye MTT, and this dye redacts to formazan crystals. The cells formed in the region of mitochondrial lactate dehydrogenase that reduces the MTT to a formazan crystals where it forms a colour purple here the number of viable cell is proportional to its intensity and those cells are estimated using spectrophotometer in 570nm.15,16
Cytotoxicity and cell proliferation – Invitro analysis
The HaCaT is A Human Skin Keratinocyte cell line, here the seed of 200µl in a well plate is allowed to grow for about 24 hrs. And then it is incubation was done in 5% of Co2 atmosphere for 24 hours. After the completion of the incubation period the media was removed from the cells are allowed for MTT reagent for 0.5 mg/ml in concentration. Over 3 hours of incubation removing of MTT reagent and addition of DMSO is done. Then the reading of absorbance was done in spectrophotometer or an ELISA reader at 570nm wavelength. And the viability of cell was estimated using different Concentration (6.25, 12.5, 25, 50, 100 and 200 µg/ml). The rapid reducing of cells can be seen in the different concentrations of the sample. The growth inhibition percentage was estimated by using the concentration of the extract need to inhibit cell growth by 50% value i.e. Ic50. 16,17 The graph curve shows the rapid decreasing of affected cell. And the % of cell viability was determine by the equation,

Results
Anti-oxidant Investigation18
DPPH Assay
DPPH assay is the familiar activity meant for the evaluation of the Antioxidant content in a sample. In the analysis the presences of anti-oxidant is identified by the decolourize. And the standard used here is rutin and BHT. The results of DDPH assay shows the ethyl acetate is high compare to ethanol. And the Fig and table 1 shows the results of DDPH scavenging assay.
![]() |
Figure 1: and Table : 1 Showing the DPPH Assay of the selected Sample Click here to View Figure |
ABTS Assay
ABTS Assay is also a measure of decolourization of the specimen. In ABTS Assay the BHT and rutin is acted as a standard. And the sample is evaluated in triplicate and after incubation the measurement of sample is at 734 nm. As the results Ethanol shows high activity compare to ethyl acetate, where the ethyl acetate is 98194.44 and ethanol is 112222.2. It is proved that plants have enormous chemical compounds in them. Here the Fig and table 2 shows the results of ABTS Assay of Sample.
![]() |
Figure 2: and Table: 2 Showing the ABTS Assay of the selected sample Click here to View Figure |
FRAP Assay
The estimation of FRAP Assay results that an ethyl acetate shows high activity than ethanol. And Rutin and BTH is used as a standard. Fig and Table 3 indicates the results of the selected samples in the following analysis.
![]() |
Figure 3: and Table: 3 Showing the FRAP Assay of the selected sample Click here to View Figure |
Anti Inflammatory Activity19
Membrane-Stabilizing assay
The membrane stabilizing assay is carried out in triplicates with the negative control. The incubation of the sample is done for 10 min at room temperature which after done for 10 min centrifugation at 3000 rpm. As the results are calculated, where the ethanol (46.46) shows the high activity compare to ethyl acetate (32.25). Fig and Table 4 is the results of membrane stabilizing assay.
![]() |
Figure 4: and Table: 4 Showing the Membrane-Stabilizing assay of the selected sample Click here to View Figure |
Anti-hemolytic activity
Hemolysis is among the common method to investigate the anti-inflammation activity. Hemolysis was estimated by the measure of OD reading was analyzed for the supernatant in 540 nm in the spectrophotometer. As a results, Where the Fig and table 5 explains the Anti-hemolytic activity ethanol sample shows high response compare to the ethyl acetate of the value 55.6 and 25.95 respectively.
![]() |
Figure 5: and Table: 5 Showing the Anti-hemolytic activity of the selected sampleAntimicrobial Activity (20). Click here to View Figure |
The antimicrobial activity was done in both the samples such as ethyl acetate and ethanol. The work was carried out in 2 gram +ve bacteria such as Staphylococcus aureus and Enterococcus faecium and gram -ve bacteria like Klebsiella pneumonia and Salmonella typhimurium and in 2 fungal organisms namely Candida tropicalis and Candida albicons . And, results was listed below in Table 6 to 9 and Picture 1-12.
Table 6: showing the Antibacterial activity in ethyl acetate of the selected sample
| Extract
Concentration (10mg/ml) |
Zone of inhibition (Staphylococcus
aureus) |
Zone of inhibition
(Enterococcus faecium) |
Zone of inhibition (Klebsiella
pneumoniae) |
Zone of inhibition (Salmonella typhimurium) | ||
| Negative control (DMSO) | – | – | – | – | ||
| 10 μ l | – | – | – | – | ||
| 15 μ l | – | – | – | – | ||
| 20 μ l | 10 | 10 | 10 | 8 | ||
| 25 μ l | 11 | 11 | 10 | 8 | ||
| 30 μ l | 12 | 10 | 11 | 10 | ||
| Positive control (Streptomycin) | 19 | 17 | 18 | 19 | ||
![]() |
Picture 1-4: Showing the Antibacterial activity in ethyl acetate of selected sample Click here to View Picture |
Table 7: showing the Antifungal activity of ethyl acetate of selected sample
| Extract Concentration
(10mg/ml) |
Zone of inhibition
(Candida tropicalis) |
Zone of inhibition
(Candida albicans) |
| Negative control
(DMSO) |
– | – |
| 10 μ l | – | – |
| 15 μ l | 7 | 8 |
| 20 μ l | 10 | 7 |
| 25 μ l | 10 | 9 |
| 30 μ l | 13 | 11 |
| Positive control
(Fluconazole) |
14 | 14 |
![]() |
Picture 5-6: Showing the Antifungal activity in ethyl acetate of selected sample Click here to View Picture |
Table 8: Showing the Antibacterial activity in Ethanol of selected sample
| Extract Concentration (10mg/ml) | Inhibition Zone (Staphylococcus aureus) | Inhibition Zone (Enterococcus faecium) | zone of inhibition (Klebsiella
pneumoniae) |
Zone of inhibition (Salmonella
typhimurium) |
| Negative control
(DMSO) |
– | – | – | – |
| 10 μ l | 9 | 9 | 9 | – |
| 15 μ l | 12 | 11 | 12 | 8 |
| 20 μ l | 13 | 10 | 13 | 9 |
| 25 μ l | 13 | 14 | 15 | 12 |
| 30 μ l | 16 | 15 | 16 | 13 |
| Positive control
(Streptomycin) |
18 | 17 | 18 | 14 |
![]() |
Picture 7-10: Showing the Antibacterial activity in Ethanol of selected sample Click here to View Picture |
Table 9: Showing the Antifungal activity in Ethanol of selected sample
| Extract Concentration
(10mg/ml) |
Zone of inhibition
(Candida Tropicalis) |
Zone of inhibition
(Candida albicans) |
| Negative control (DMSO) | – | – |
| 10 μ l | 6 | 8 |
| 15 μ l | 9 | 9 |
| 20 μ l | 12 | 10 |
| 25 μ l | 13 | 12 |
| 30 μ l | 13 | 12 |
| Positive control (Fluconazole) | 18 | 15 |
![]() |
Picture 11-12: Showing the Antifungal activity in Ethanol of selected sample. Click here to View Picture |
Cytotoxicity and cell proliferation – Invitro analysis (HaCaT – Human Skin Keratinocyte cell)
To appraise the source in H. fischeri on development of HaCaT, The cells were studied in the different concentration such as 6.25, 12.5, 25, 50, 100 and 200. And the reduction of toxic cells
have taken place in the increasing of concentration. Where the concentration 6.25 shows 94.65% of cells, 12.5 shows 90.25% of cells, 25 shows 82.37% of cells, 50 shows 78.40%, 100 shows 51.87% and 200 shows 5.08%. So this rapid decrease indicates that the sample has the capacity of anti-aging property in it. And the results was listed below in Table 10, Fig 6 and Picture 13 to 19.21
![]() |
Figure 6: and Table 10: MTT Assay of HaCaT in Ethanol extract. Click here to View Figure |
![]() |
Picture: 13-19: MTT Assay of HaCaT in Ethanol extract Click here to View Picture |
Discussion
The results secured from the followed activities proves that the selected medicinal plant sample has an enormous properties of antioxidant, anti-inflammation and antimicrobial content whereas the HaCaT cells prove that the sample has the ability of work against the aging and skin
diseases. Now-a-days the world facing an indirect problem which is aging at early stage. So this observation helps the researchers to find a new beginning to proceed.22,23 And the above estimation have also discuss about the different assay like DDPH, FRAP and ABTS in the antioxidant activity which ensure that the selected solvent both ethanol and ethyl acetate of Henckelia fischeri (Gamble) A. Weber & B. L. Burtt has a wealthy source of antioxidant in it. Whereas the anti-inflammation property was done in 2 assay including Anti-hemolytic and Membrane stabilizing assay proves that the sample inhibits the nature against inflammation.24 The microbial work was carried out in both gram +ve and –ve bacteria and fungal which proves that specimen work against them in a sterile condition and proves that it is antimicrobial specimen.25,26 With the following results the work undergone to the check the cell viability in a fibroblast cells, the cell specified was HaCaT it is a Human Skin Keratinocyte and this cell was allowed to identify its viability at different concentration such as 6.25, 12.5, 25, 50, 100 and 200. Where the decreasing of cell can be seen, in other words increasing of concentration leads to increase of cell viability.27 Hence from the discussion part, the study reveals that the specimen selected has countless medicinal resources and they have also proved the presences of secondary metabolities like phenol, tannin, flavonoid and Alkaloid which is the lead to the pharmaceutical world.
Conclusion
It study can be terminate the leaf extracts from the selected medicinal plant H. fischeri (Gamble) A. Weber & B. L. Burtt of Gesneriaceae, has the property of antioxidant, anti – inflammation and antimicrobial activity in the high quantity. And this study is conclude that the ethanol solvent of plant extract has rich activity compare to that of ethyl acetate in all the three properties such as antioxidant, anti-inflammation and antimicrobial. The HaCaT shows the highest rate of proliferation at the 200 concentration. And futher work was going in the same plant. Hence this plant has high medicinal uses and this could utilize in the diagnosis of numerous diseases. Therefore, additional investigation is necessitate to pinout and pindown the compounds present in the plant extract prior to clinical use and to establish the therapeutic value.
Acknowledgement
The acknowledgement section is a phase to impress my gratitude to those who helped and contributed, I would like to show my gratitude to all the author’s who work in this paper. In addition to Nirmala College for women and Sasi Bioprospecting Laboratory, Coimbatore, Tamil Nadu, India.
Funding Sources
The author(s) received no financial support for the research, authorship, and/or publication of this article.
Conflict of Interest
The author(s) do not have any conflict of interest.
Data Availability Statement
This statement does not apply to this article.
Ethics Statement
This research did not involve human participants, animal subjects, or any material that requires ethical approval.
References
- Ignace Kindo; John Britto S.; Thamacin Arulappan M.; Sinjumol Thomas. European Journal of Biomedical and Pharmaceutical Sciences, 2014, 1(2), 190-198.
- Faysal, Fahadul Islam.; Anwar Parvez.; Susmita Saha.; Nusrat Jahan Sugandha.; Abdur Rahman.; Shaila Sultana.; Zamshed Alam Begh.; Mominur Rahman.; Azad A. K. World Journal of Pharmaceutical Research, 2020, 9(4), 16-25.
- Kindo I.; Britto S J.; Arulappan M T.; Thomas S. International Journal of Biology, Pharmacy and allied sciences, 2014, 3(9), 2170-2175.
- Marimuthu Krishnaveni.; Ravi Dhanalakshmi. International Journal of Pharmaceutical Sciences Review and Research, 2014, 29(1), 95-
- Anca I. Isaia (oarcea).; Ioana M.C.; Ienascu1.; Florina M. Andrica.; Doina Georgescu.; Daniela Bratosin.; Iulia A. Pinzaru. CHIM.(Bucharest), 2016, 60(8), 1633-1636.
- Wickramasinghe P. C. H.; Seran T. H.; Senarathne M. M. D. J. Bangladesh Journal of Scientific and Industrial Research, 2021, 56(3), 177-184.
CrossRef - Janeesha A.P.; Nampy S. Journal of the Indian Association for Angiosperm Taxonomy, 2020, 30(1), 48–95.
- Blois M. Nature, 1958, 181, 1199–1200.
CrossRef - Re R.; Pellegrini N.; Proteggente A.; Pannala A.; Yang M.; Rice-Evans C. Med, 1999, 26(9- 10), 1231–1237.
CrossRef - Pulido R.; Bravo L.; Sauro-Calixto F. Agricult. Food Chem, 2000, 48(2), 3396- 3402.
CrossRef - Chandra ; Chatlod, L. R.; Kumar S.; Toppo S.; Haque N.; Rahman H. Indian J. Small Rum, 2012, 18 (2), 261-263.
- Cao M.; Lu X.; Wu K. Sig Transduct Target Ther, 2012, 6(1), 371-375.
- Tendencia, E. A.; Tigbauan, Iloilo. Philippines: Aquaculture Department, Southeast Asian Fisheries Development Center 2012.
- Heatley G.; Biochemical journal, 1944, 38(1),61-5. doi: 10.1042/bj0380061
CrossRef - Zofia Nizioł Łukaszewska.; Dominika Furman-Toczek.; Martyna Zagórska-Dziok. Lipids in Health and Disease, 2018, 17(280), 1-12.
CrossRef - Susanikova I.; Puchlova M.; Lachova V.; Svajdlenka E.; Mucaji P.; Smetana K.; Gal P. Folia Biologica, 2019, 65, 24-35.
CrossRef - Murat Türkoğlu.; Cihat Dündar.; Hakan Sevinç.; Songül Kılıç. American Journal of Dermatology and Venereology, 2017, 6(1), 6-10.
- Baiano A.; Terracone C.; Gambacorta G. Am. Oil Chem. Soc. 2009, 86(8), 1083 – 1092.
CrossRef - Anosike C ; Obidoa O.; Ezeanyika L U. J. Pharmaceut. Sci. 2012, 20(1), 76-80.
CrossRef - Raja Ratna Reddy Y.; Krishna Kumari C.; Lokanatha O.; Mamatha S.; Damodar Reddy C.; International Journal of Research in Phytochemistry & Pharmacology, 2013, 3(1), 1-4.
- Cohen G.; Raz O.; Fahham A.; Lan D.; Eshar S.; Bentwich Z.; Shtevi A. Negev, Dead Sea and Arava Studies, 2015, 7 (3), 66–74
- Mosquera O ; Correa Y M.; Buitrago D C.; Nino J. Memórias Do Instituto Oswaldo Cruz, 2007, 102(5), 631– 634.
CrossRef - Siddhuraju P.; Mohan P S.; Becker K. Food Chem. 2002, 7(9), 61-67.
CrossRef - Tripa ; Bishakha Chowdhury.; Tapash Kumar Bhowmik.; Md Mahbubur Rahman. J. Orchid Soc. India, 2022, 36: 29-33,
CrossRef - Ebtihal Alsadig Ahmed Mohamed.; Ali Mahmoud Muddathir.; Magda Abker Osman. Nature research, 2020, 10:17148.
- Thejanuo Rhetso.; Shubharani R.;. Roopa M. S.; Sivaram V. Future Journal of Pharmaceutical Sciences, 2020, 6:102.
CrossRef - Kwanchanok Wadkhien.; Chatchai Chinpaisal.; Malai Satiraphan.; Penpan Wetwitayaklung.; Nushjira Pongnimitprasert. Science, Engineering and Health Studies, 2018, 12(1), 19-32.
Accepted on: 12 Aug 2025
Second Review by: Dr. Rashim Mohhamad
Final Approval by: Dr. Pounraj Thanasekaran